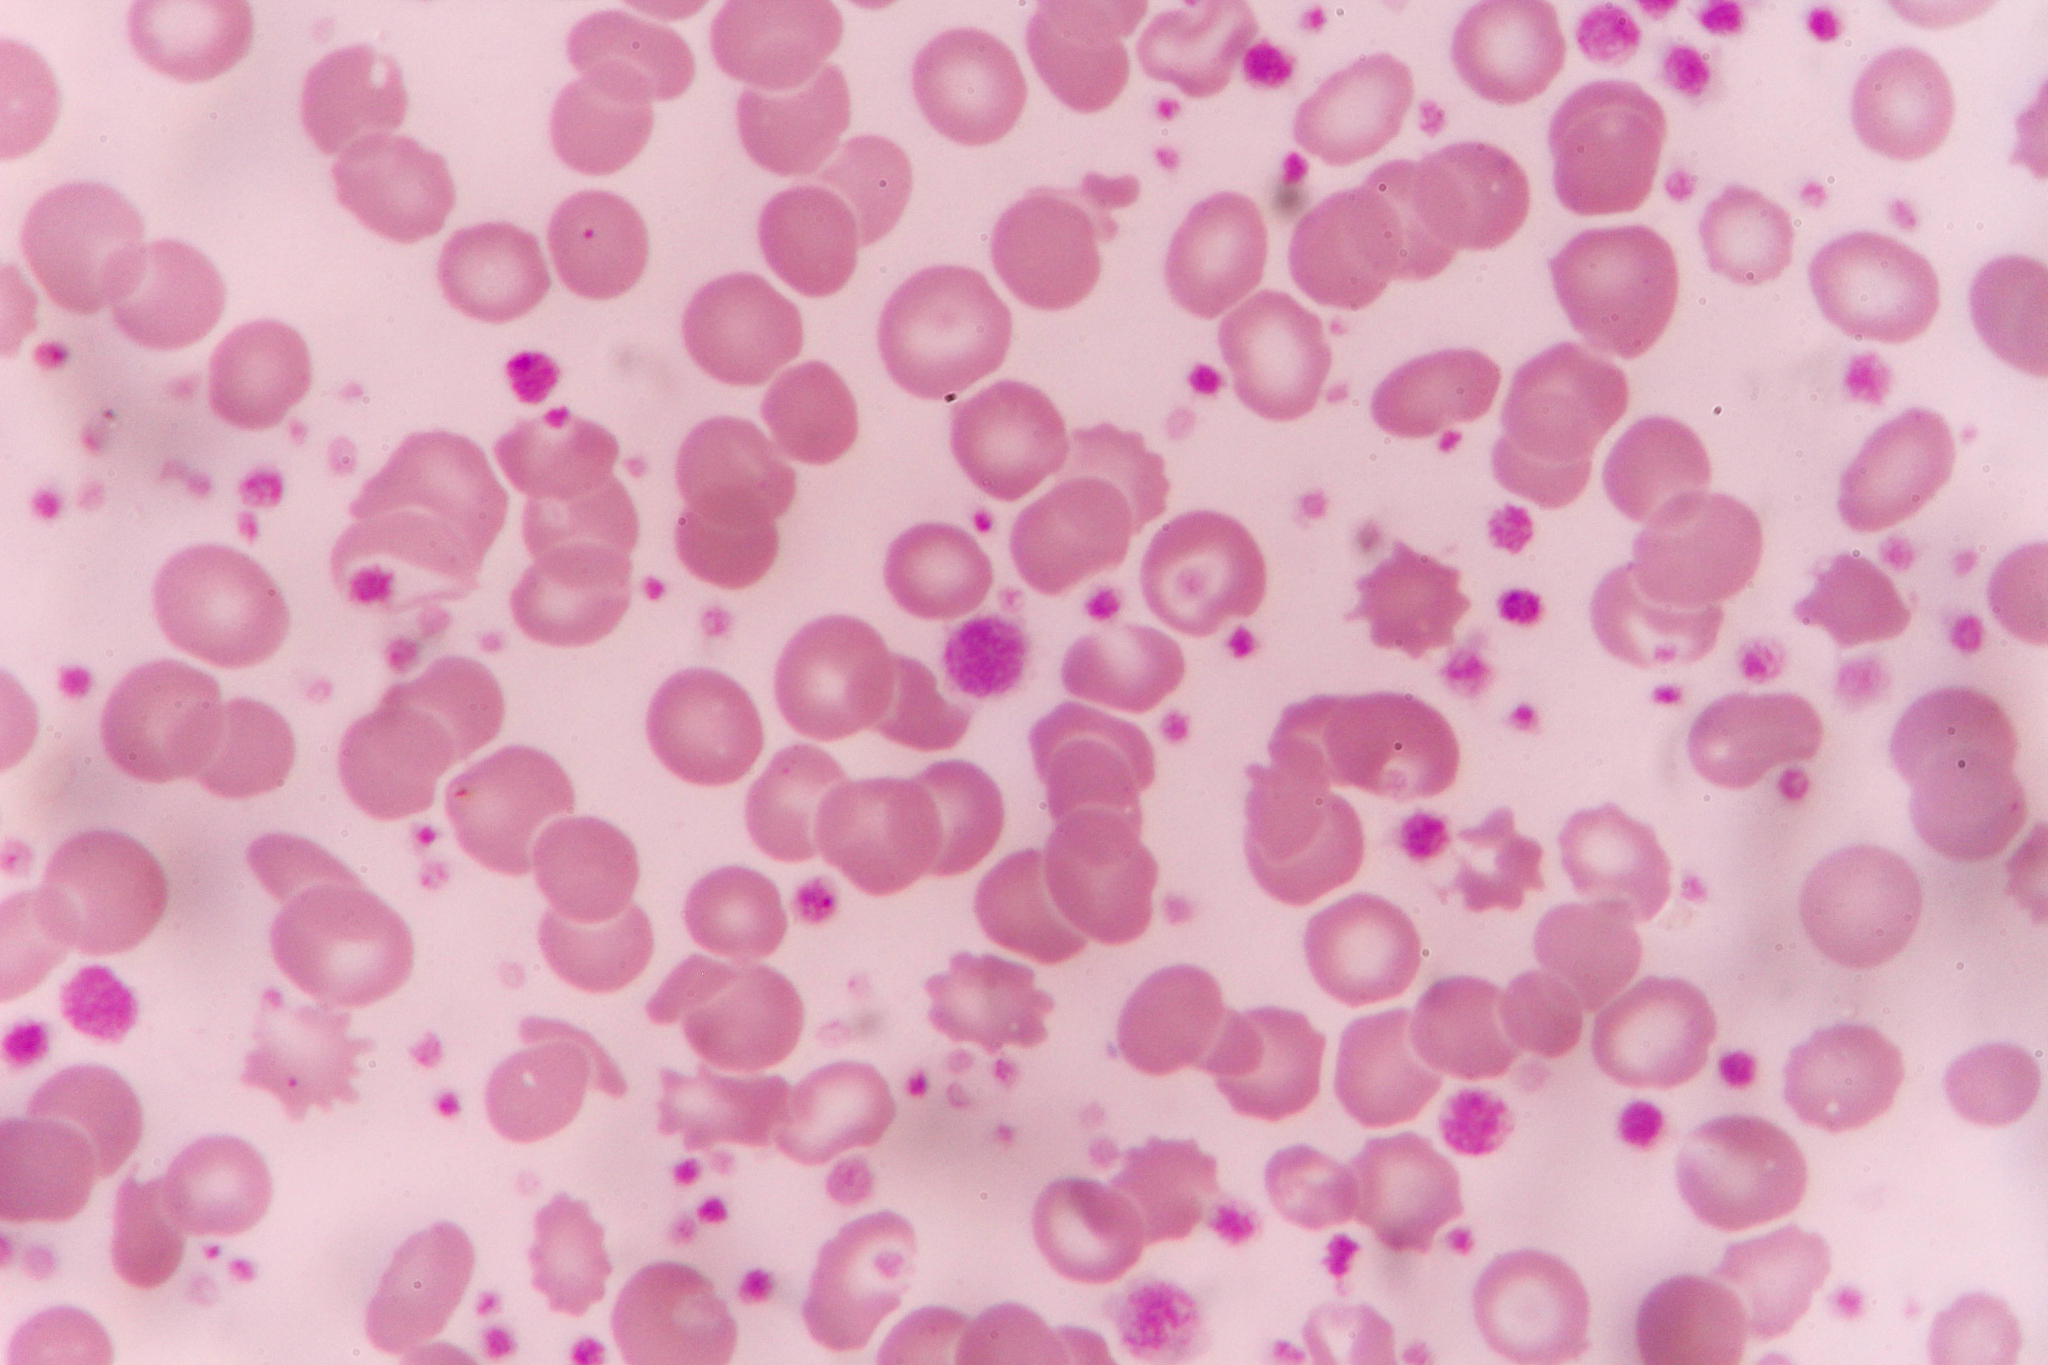
再生性贫血：症状、检查和诊断

再生性贫血:症状、检查和诊断
再生性贫血是一种由于骨髓功能障碍导致的贫血。其临床表现包括疲乏、头晕、心悸、呼吸困难、皮肤苍白等,严重的病例还可能出现肝脾肿大、感染等症状。
实验室检查中,再生性贫血患者的外周血象表现为贫血、白细胞计数减少、血小板计数减少。骨髓象显示红系细胞减少、巨核细胞减少或缺失。同时,还需排除其他原因引起的贫血,如缺铁性贫血、巨幼细胞性贫血等。
再生性贫血的诊断需要结合临床症状、实验室检查及骨髓活检等综合分析。治疗方面,可采用输注红细胞、血小板及白细胞、使用免疫抑制剂等方法。
原文地址: https://www.cveoy.top/t/topic/mOj0 著作权归作者所有。请勿转载和采集!